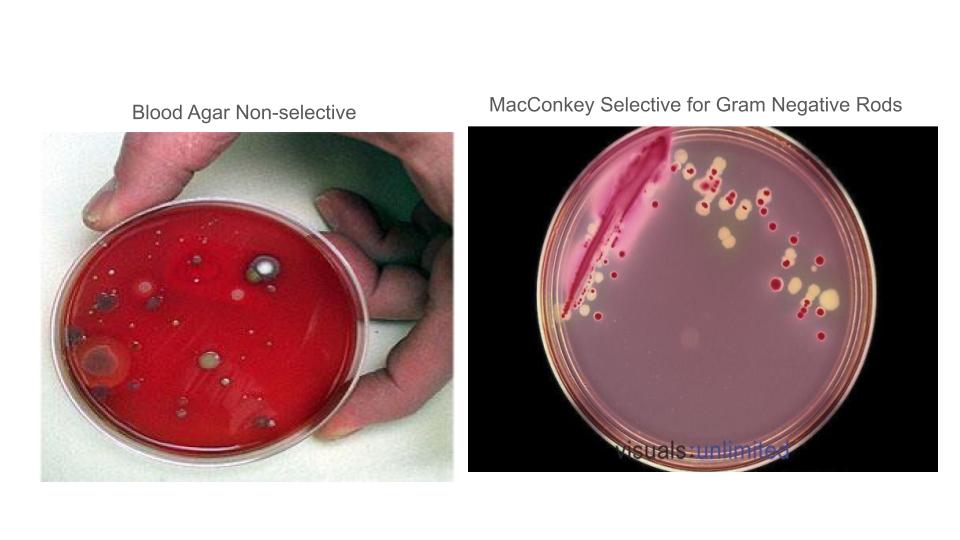

Standards RST.9-10.1 CCC: Systems DCI: LS1.A
Standards RST.9-10.1 CCC: Systems DCI: LS1.A
Following inoculation of a specimen onto a culture medium, which of the following is the most immediate and critical next step in the process of culturing microorganisms?
Which of the following methods is used to grow bacteria in a laboratory setting under controlled temperature conditions?
A microbiologist is trying to identify a specific bacterial species by observing its requirements for nutrients and atmospheric conditions. What technique are they employing?
Selective media is designed to promote the growth of a specific type of microorganism by:
Differentiation in media helps to identify bacteria by allowing for the visualization of their:
An organism with complex nutritional requirements that cannot grow on a basic nutrient agar is known as a fastidious organism. This type of organism must be grown on a(n):
Which of the following isolation techniques is considered the most effective and widely used for obtaining pure bacterial cultures from a mixed sample?
In a microbiology lab, media can be prepared in three physical forms. These forms are:
Proper handling of bacterial cultures in a laboratory setting is crucial for what primary reason?
A microbiologist inoculates Staphylococcus epidermidis and Escherichia coli onto a culture medium. Following incubation, only the E. coli grows in the culture. What is the most likely explanation?
A common medium used for growing fastidious bacteria is...
Which type of medium is able to distinguish different species or types of microorganisms based on an observable change in the colonies or in the medium?
A mixed culture is a sample that contains...
A microbiologist inoculates Staphylococcus aureus into a culture medium. Following incubation, both Staphylococcus aureus and Staphylococcus epidermidis are found to be growing in this culture. What is the most likely explanation?
NCLEX Prep - Test Bank Question: Please read the clinical scenario, and then answer the questions that follow to become familiar with the traditional NCLEX question format.
You begin your shift at the irmer city outreach clinic when a young woman enters crying. She is 19 years old and 28 weeks pregnant with her second child. Her complaint is that she woke this morning leaking clear to milky-colored fluid vaginally. Her first child was born 6 weeks early due to premature rupture of membranes and she is worried this is happening again. You reassure the patient, and explain that a vaginal speculum exam will be performed and specimens will be taken for examination. Once obtaining the proper specimens, you label them appropriately, and send the wet mount and culturette to the laboratory for processing.
The patient asks how microbes from her body can be grown in the lab. You explain that specimens are introduced to nutrient medium and that any growth of the microbe that appears after incubating the specimen is called the
PE/Data: Use the data to explain the question below. Worth 5 points.
The above plates come from the same specimen. Based on the provided data, what preliminary microbiological information can you provide to the doctor regarding the organisms growing on these two plates? Be sure to use appropriate terminology to describe the different media and the observed results. Your response should address how the use of selective media vs. non-selective media helps you to reach these conclusions.
CCC: Cause and Effect

Mistakes in the Inoculation, Isolation, and Inspection steps of the 5 I's can significantly impact the final Identification of a microbe. Discuss a potential error that could occur in each of these three steps. For each error, explain how it would specifically affect your understanding of a patient's disease and propose a method to prevent or mitigate the mistake.
CER: Make a claim, use evidence to support your claim, and explain your reasoning (the why(s) for your claim).
Tip: Read the information closely.
A patient comes into the hospital with a suspected kidney infection. The doctor orders a test in which lung tissue is extracted from the patient and is sent to the microbiology for testing. The culture results show gram negative organisms growing. The patient is treated with antibiotics for the infection but dies. An autopsy is performed showing the lungs had a gram-positive organism infection.

You have been called as an expert witness in a court case. The lawyer for the prosecution claims that since the kidney is a sterile organ, any bacterial growth from a tissue sample must be considered a pathogen, and the lab must have made a mistake in identifying a different cause of death. Based on the provided Gram stain images from the original lung specimen and a lung autopsy, construct a CER argument for the court.
Claim: Directly answer the question: Did the lab likely make a mistake?
Evidence: Use specific observations from the Gram stain images and information to support your claim.
Reasoning: Use your knowledge of microbiology, specifically Gram staining and sterile sites and potential sources of error, to explain how your evidence proves your claim.
See the rubric to ensure you get the greatest amount of points for your answer.